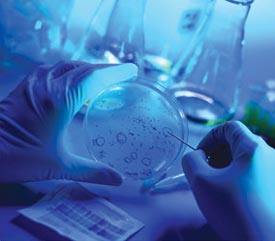
Research

|
New Look Of Fanconi Anaemia UK:
Welcome to the new look website of www.fanconi-anaemia.co.uk. We have decided to give the old site a bit of a face lift and we hope that you agree with the new cleaner look
and line of the new site.
If you are a Nurse, Doctor, Paediatrician, Haemotologist or Geneticist looking for some help or advice with an
FA patient click here to go to the page with all the information and contact numbers you will need.
( This is Designed for Professional Personnel Only, Not the General Public. These Peoples Time SAVES Lifes DON'T waste it )
Aims :
There are two aims to this site. Firstly to give information about the condition, and how it will effect those that have been diagnosed as having it, along with their families and friends. Secondly to give Doctors and Physicians up to date information regarding research and treatment for FA. Patients from leading specialists in the UK, Europe and the US.
(remember a lot of doctors will not have heard of this condition)
|
This Site :
What this site is intended for .
- To Help families and friends of FA sufferers
- Give you a means of contact with another family or person who knows what you are going through
- Give the Medial profession information that is up to date
- Give hope and understanding to everyone concerned with FA
|
Disclaimer:
All information on this site is accurate at time of publication. Any person havng any queries regarding the content of this site should contact the WebMaster by email at [email protected] any other questions should be taken up with your doctor or specialist.
|